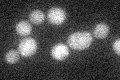
YIL107C
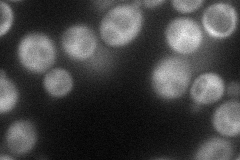
YIL107C
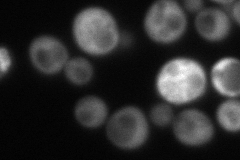
YIL107C
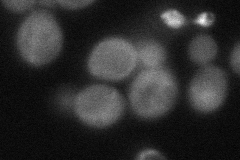
YIL107C
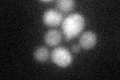
YIL107C

View description
6-phosphofructo-2-kinase, inhibited by phosphoenolpyruvate and sn-glycerol 3-phosphate; has negligible fructose-2,6-bisphosphatase activity; transcriptional regulation involves protein kinase A
Localization:
Intensity:
Fold change:
Significance:
-
C’ GFP library in SD
cytosol19.71 -
N' NOP1pr-GFP in SD
cytosol70.9792 -
N' TEF2pr-mCherry in SD
cytosol108.098 -
N' NATIVEpr-GFP in SD

cytosol37.3523 -
N' TEF2pr-VC and Cyto-VN in SD
cytosol53.9561 -
C’ GFP library in SD+DTT
cytosol20.351.03No -
C’ GFP library in SD+H2O2

cytosol19.791No -
C’ GFP library in Starvation Media

cytosol23.81.2No -
C’ GFP library on the background of Pup2-DaMP

N/A -
C’ GFP library on the background of CCT mutant

N/A0N/AYes
